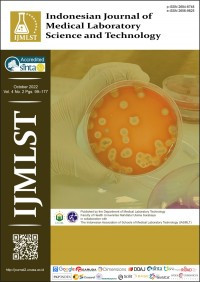
Image of Indonesian Journal Of Medical Laboratory Science and Technology Vol.4 No.2 Oktober 2022

Text
Indonesian Journal Of Medical Laboratory Science and Technology Vol.4 No.2 Oktober 2022
Tidak Tersedia Deskripsi
Ketersediaan
#
Almari Kabinet (Almari 05 Rak Ketiga)
616.07 DUR i
AAKJ648
Tersedia
Informasi Detail
- Judul Seri
-
-
- No. Panggil
-
616.07 DUR i
- Penerbit
- Surabaya : Unusa Press., 2022
- Deskripsi Fisik
-
77 hlm; 30 cm
- Bahasa
-
Inggris
- ISBN/ISSN
-
2656-9825
- Klasifikasi
-
616.07
- Tipe Isi
-
-
- Tipe Media
-
-
- Tipe Pembawa
-
-
- Edisi
-
-
- Subjek
- Info Detail Spesifik
-
Koleksi Referensi
- Pernyataan Tanggungjawab
-
-
Versi lain/terkait
Tidak tersedia versi lain
Lampiran Berkas
Tidak Ada Data
Komentar
Anda harus masuk sebelum memberikan komentar
Karya Umum
Karya Umum  Filsafat
Filsafat  Agama
Agama  Ilmu-ilmu Sosial
Ilmu-ilmu Sosial  Bahasa
Bahasa  Ilmu-ilmu Murni
Ilmu-ilmu Murni  Ilmu-ilmu Terapan
Ilmu-ilmu Terapan  Kesenian, Hiburan, dan Olahraga
Kesenian, Hiburan, dan Olahraga  Kesusastraan
Kesusastraan  Geografi dan Sejarah
Geografi dan Sejarah